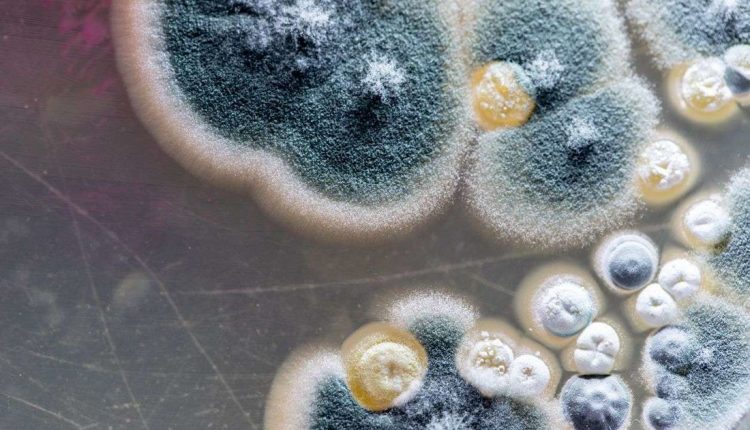

Após caso de mucormicose, o “fungo preto”, Sesap esclarece sobre sintomas e qual tratamento da doença
A Secretaria de Estado da Saúde Pública (Sesap), por meio da Subcoordenadoria de Vigilância Epidemiológica (Suvige), informou o monitoramento de um caso confirmado de mucormicose, infecção fúngica conhecida como fungo preto, em uma paciente com histórico de Covid-19 e divulgou informações sobre o que é, os sintomas e tratamento da doença.
A Suvige acompanha a situação clínica da paciente com 42 anos que teve o resultado positivo para micormicose, detectado por meio de uma biópsia. A equipe está avaliando também seus exames e histórico clínico.
Mucormicose
A mucormicose é causada por fungos da ordem Mucorales, e foi identificada pela primeira vez em 1885. Esses fungos podem estar presentes no ar, na água, em diversos ambientes. Podem acometer principalmente pessoas com o sistema imunológico deprimido, uma vez que os fungos são oportunistas, aproveitando-se da baixa imunidade para se instalar no organismo. Dessa forma, imunossuprimidos, diabéticos e pacientes internados em UTI são mais vulneráveis à mucormicose.
Os fungos Mucorales são transportados pelo ar e a infecção costuma ocorrer pela inalação de seus esporos ou, ainda, por meio de uma laceração na pele, como cortes ou queimaduras. A doença começa a se manifestar como infecção de pele nas bolsas de ar localizadas atrás da testa, nariz, maçãs do rosto e entre os olhos e os dentes.
Em seguida, o fungo pode se espalhar para os olhos, pulmões, podendo atingir também o cérebro. Isso leva ao escurecimento ou descoloração do nariz, visão turva ou dupla, dor no peito, dificuldades respiratórias e tosse com sangue. Ao atingir os vasos sanguíneos da via área e dos seios da face, o fungo compromete a circulação do sangue até necrosar os tecidos nestes locais.
Tratamento
A doença é tratada por meio de medicamentos antifúngicos. Quando a infecção chega ao estágio de necrose, as áreas afetadas precisam ser removidas por meio de cirurgia. O diagnóstico precoce e início imediato do tratamento adequado é fundamental para aumentar as chances de cura da doença, que apresenta uma taxa de letalidade de 50 a 60%.
Relação entre mucormicose e Covid-19
Os estudos acerca da relação entre a mucormicose e a Covid-19 ainda estão em fase inicial, mas os infectologistas acreditam que a ocorrência da doença em pacientes com histórico de Covid-19 esteja relacionada ao seu estado debilitado, acometendo principalmente pacientes hospitalizados e em estado grave.